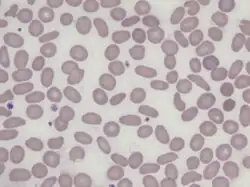

Elliptocyte
| Cigar cells in elliptocytosis | |
|---|---|
![]() | |
| Blood smear showing elliptocytes | |
| Specialty | Hematology |

Elliptocytes, also known as ovalocytes or cigar cells, are abnormally shaped red blood cells that appear oval or elongated, from slightly egg-shaped to rod or pencil forms. They have normal central pallor with the hemoglobin appearing concentrated at the ends of the elongated cells when viewed through a light microscope. The ends of the cells are blunt and not sharp like sickle cells.[1]
Elliptocytes are commonly associated with hereditary elliptocytosis. However, they may also be seen in iron deficiency anemia, sepsis, malaria and other pathological states that decrease red blood cell turnover and or production.[2] In the case of iron deficiency anemia, microcytosis and hypochromia would also be expected.[3]
Causes
Rare elliptocytes (less than 1%) on a peripheral blood smear are a normal finding.
These abnormal red blood cells are seen in higher numbers in the blood films of patients with blood disorders such as:[4]
- Hereditary elliptocytosis and Southeast Asian ovalocytosis
- Thalassemia
- Iron deficiency
- Myelodysplastic syndrome and myelofibrosis
- Megaloblastic anemia
References
- ^ "Ovalocytes/Elliptocytes - LabCE.com, Laboratory Continuing Education". www.labce.com. Retrieved 21 May 2018.
- ^ Clinical hematology and oncology : presentation, diagnosis, and treatment. Bruce Furie. Philadelphia, Pa.: Churchill Livingstone. 2003. pp. 276–278. ISBN 0-443-06556-X. OCLC 51582525.
{{cite book}}: CS1 maint: others (link) - ^ Robbins & Cotran pathologic basis of disease. Vinay Kumar, Abul K. Abbas, Jon C. Aster, James A. Perkins (10th ed.). Philadelphia, PA. 2021. ISBN 978-0-323-53113-9. OCLC 1191840836.
{{cite book}}: CS1 maint: location missing publisher (link) CS1 maint: others (link) - ^ Hirschmann, Douglas C. Tkachuk (2007). Wintrobe's atlas of clinical hematology. Philadelphia, PA [etc.]: Lippincott Williams & Wilkins. ISBN 978-0781770231.
